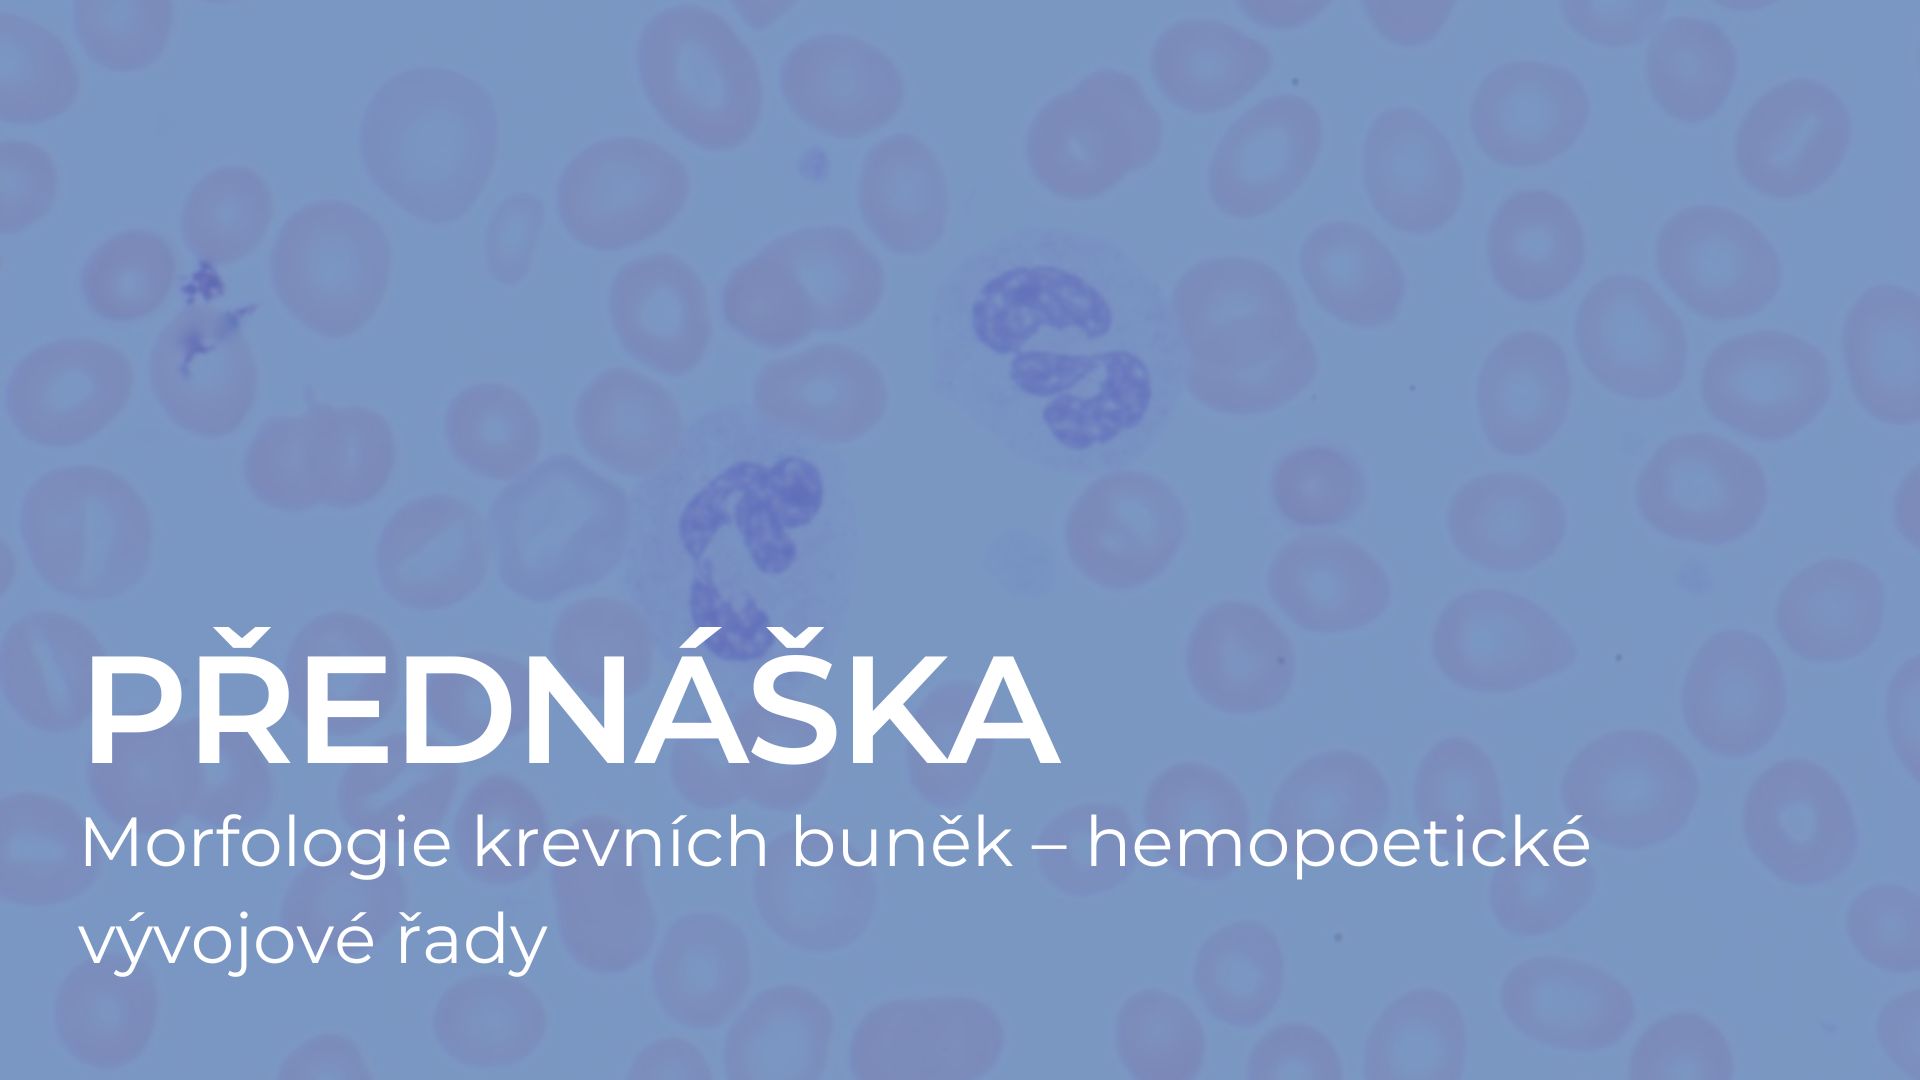

| |
|
|
|
Žádné události, pátek, 1. května
1
Žádné události, pátek, 1. května
1
|
Žádné události, sobota, 2. května
2
Žádné události, sobota, 2. května
2
|
Žádné události, neděle, 3. května
3
Žádné události, neděle, 3. května
3
|
|
Žádné události, pondělí, 4. května
4
Žádné události, pondělí, 4. května
4
|
Žádné události, úterý, 5. května
5
Žádné události, úterý, 5. května
5
|
Žádné události, středa, 6. května
6
Žádné události, středa, 6. května
6
|
Žádné události, čtvrtek, 7. května
7
Žádné události, čtvrtek, 7. května
7
|
Žádné události, pátek, 8. května
8
Žádné události, pátek, 8. května
8
|
Žádné události, sobota, 9. května
9
Žádné události, sobota, 9. května
9
|
Žádné události, neděle, 10. května
10
Žádné události, neděle, 10. května
10
|
|
Žádné události, pondělí, 11. května
11
Žádné události, pondělí, 11. května
11
|
Žádné události, úterý, 12. května
12
Žádné události, úterý, 12. května
12
|
Žádné události, středa, 13. května
13
Žádné události, středa, 13. května
13
|
Žádné události, čtvrtek, 14. května
14
Žádné události, čtvrtek, 14. května
14
|
Žádné události, pátek, 15. května
15
Žádné události, pátek, 15. května
15
|
Žádné události, sobota, 16. května
16
Žádné události, sobota, 16. května
16
|
Žádné události, neděle, 17. května
17
Žádné události, neděle, 17. května
17
|
|
Žádné události, pondělí, 18. května
18
Žádné události, pondělí, 18. května
18
|
Žádné události, úterý, 19. května
19
Žádné události, úterý, 19. května
19
|
Žádné události, středa, 20. května
20
Žádné události, středa, 20. května
20
|
Žádné události, čtvrtek, 21. května
21
Žádné události, čtvrtek, 21. května
21
|
Žádné události, pátek, 22. května
22
Žádné události, pátek, 22. května
22
|
Žádné události, sobota, 23. května
23
Žádné události, sobota, 23. května
23
|
Žádné události, neděle, 24. května
24
Žádné události, neděle, 24. května
24
|
|
Žádné události, pondělí, 25. května
25
Žádné události, pondělí, 25. května
25
|
Žádné události, úterý, 26. května
26
Žádné události, úterý, 26. května
26
|
Žádné události, středa, 27. května
27
Žádné události, středa, 27. května
27
|
Žádné události, čtvrtek, 28. května
28
Žádné události, čtvrtek, 28. května
28
|
Žádné události, pátek, 29. května
29
Žádné události, pátek, 29. května
29
|
Žádné události, sobota, 30. května
30
Žádné události, sobota, 30. května
30
|
Žádné události, neděle, 31. května
31
Žádné události, neděle, 31. května
31
|